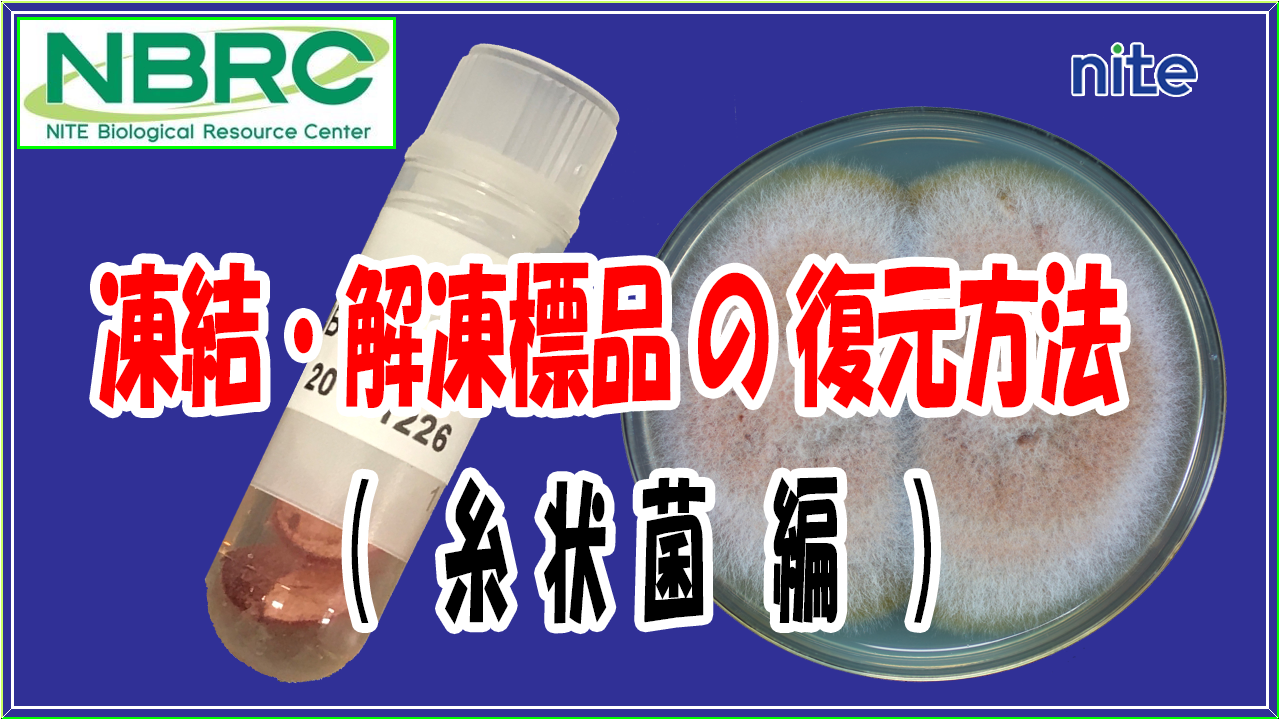
凍結解凍標品復元
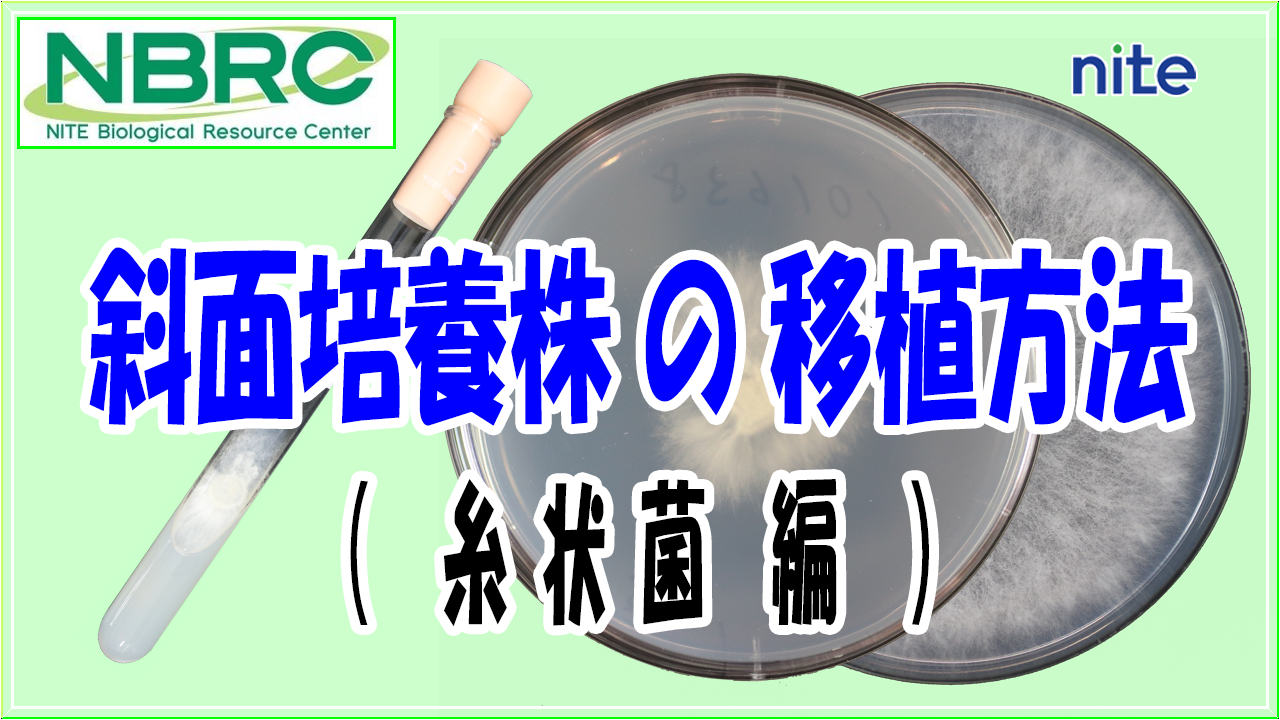
斜面培養株移植

画像、動画
独立行政法人製品評価技術基盤機構バイオテクノロジーセンター(NBRC)が提供する微生物画像や動画へのリンクを示しております。
ご利用になりたいサービスのリンクをクリックしてください。
動画
講演会・セミナー等動画
NITE講座 「微生物の利活用基礎講座2025 ~バイオものづくりに向けた微生物取り扱い(培養・保存)の実践スキルの習得~」第1部 微生物の培養及び保存方法の講義動画です。
- ●NITE講座の詳細は以下のページよりご確認ください。(講義資料の公開も行っています。)
- 「微生物の利活用基礎講座2025 ~バイオものづくりに向けた微生物取り扱い(培養・保存)の実践スキルの習得~」
業務・施設紹介ほか各種動画
お問い合わせ
- 独立行政法人製品評価技術基盤機構 バイオテクノロジーセンター 計画課 バイオ戦略・広報室
-
TEL:03-3481-1933
住所:〒151-0066 東京都渋谷区西原2-49-10 地図
お問い合わせフォームへ